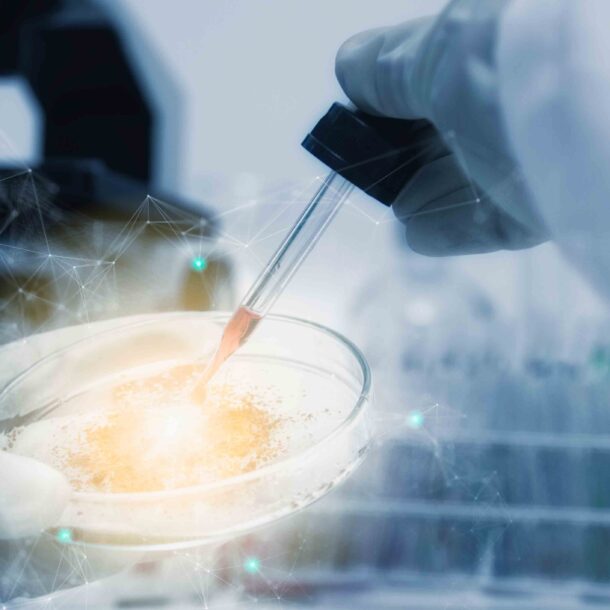

-
Recent Insights
Archives
Categories
Don’t let “good enough” be the enemy of “good.” One of the areas in which we have begun engaging clients is with the assessment of whether they are actually taking full advantage of the tax determination software they already have installed. In the haste to meet project deadlines or to simply get something into production for “tweaking” later many software implementations opt to go live with the minimal feature set. This results in manual workarounds and additional labor that rolling out new software was supposed to help reduce.
We’ve seen manual creation of tax rules versus mapping products and services to the existing tax tables. We’ve seen exemption certificates tracked on spreadsheets out of concern that the software will change a client’s tax status without notice. Once workarounds are put in place momentum leaves them untouched until a bandwidth crisis causes a review of how to get more done with the team at hand.
A service TekDominion offers is to review any or all processes associated with VAT, Sales and Use Tax and offer technology or organization fixes to streamline operations. Sometimes there are new features in new versions that can be used for no additional cost other than the time to make a few config changes. Sometimes there is manually intensive labor that should be considered for outsourcing.
A little time spent when things are calmer, and not in crisis mode, can deliver huge savings and perhaps avoid a bandwidth crisis altogether.